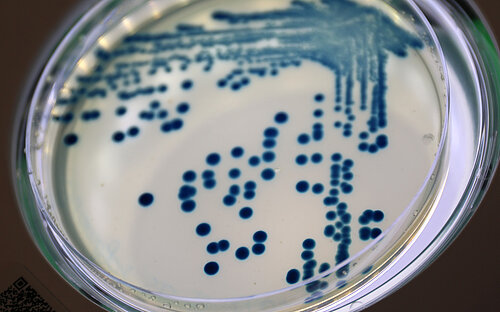
Dot-like colonies of the bacterium Klebsiella pneumoniae (blue) on a round plate

Antibiotic resistance

Since the mid-1940s antibiotic resistance has spread. Infections with multiresistant germs are increasing worldwide. Already today up to 95 percent of the Staphylococcus aureus strains are resistant. This means that an important pillar of our modern health research is breaking away.
Are antibiotics the magic bullet of medicine? Well, yes ... and no. Yes, because medications that inhibit the growth of bacteria or kill them revolutionised medicine and saved innumerable human lives. No, or more precisely no longer, because the microorganisms inevitably develop resistance against these agents. The magic bullets lose their magic effect quickly and can be used for a limited time only.
Resistance to antibiotics is a natural phenomenon. Bacteria that are insensitive to antimicrobial substances have a survival advantage over sensitive bacteria and their proliferation is therefore favoured. Some forms of resistance arise in nature without any human influence: Since some microorganisms produce antibiotics for protection against other bacteria, the latter often developed mechanisms to escape this effect. However, the use and abuse of antibiotics in human and veterinary medicine has a much more marked influence.
How does resistance develop? One possibility is by spontaneous mutations. When bacteria replicate their genes they make errors occasionally. Since genes are a blueprint for the production of proteins, the change in the gene may lead to a change in the protein, which might in turn make the organism insensitive to a certain medication. The change might prevent the antibiotic from reaching the inside of the cell or it might transport it out of the cell again. Also a change of the target of the antibiotic in the cell might lead to the medication becoming ineffective. In addition, bacteria have ways of passing resistance genes on to other bacteria. This works, for example, when two cells are in direct contact in a process called conjugation. Viruses can also transfer these genes.
Through these pathways, bacteria can acquire multiple resistances and thus become insensitive to different antibiotics. This results in multi-resistant pathogens, one of the major challenges faced by physicians to date. The World Health Organisation (WHO) estimates that about four percent of all new cases of tuberculosis are due to a strain of pathogen that can no longer be treated with the common medications. Only about half of these cases can be treated successfully through long-term administration of multiple agents, often with considerable adverse effects. Physicians are observing similar problems with many pathogens they typically encounter in hospital settings. One example: Staphylococcus aureus, which can be detected in about one third of all people in the world and is a hazard for individuals with a weakened immune system. Approximately one percent of the cases concern multi-resistant variants that are difficult to treat.

The therapy of infections that are due to resistant pathogens usually takes longer, which means that the infection may be transmitted to more people. Treatment is more expensive and associated with hospital stays, loss of working hours and a reduced quality of life. The more antibiotics lose their effect, the more the achievements of modern medicine are in jeopardy. Many surgeries, especially transplantations, are virtually impossible without these agents.
The fight against this trend requires concerted action by physicians, veterinarians, animal breeders, regulatory authorities, politicians–and scientists. There is an urgent need for new antibiotics and alternative anti-microbial drugs.
Researchers at the HZI investigate various aspects of resistance. They research the interaction between host and pathogen as the foundation for the development of new strategies against these germs. This includes substances which do not lead to resistance in bacteria because they elicit no selective pressure. This is the case, when these substances render the microorganisms less pathogenic without killing them. The researchers are also looking for ways allowing them to interrupt existing mechanisms of resistance development and they study on a population level how widespread resistant pathogens are. In addition, there are several research groups directly searching for new agents and developing them into new antibiotics.
(bma)
Involved research groups
-
Chemical Biology
 Prof Dr Mark Brönstrup
Prof Dr Mark Brönstrup -
Epidemiology and Ecology of Antimicrobial Resistance
 Prof Dr Katharina Schaufler
Prof Dr Katharina Schaufler -
Actinobacteria Metabolic Engineering
 Dr Andriy Luzhetskyy
Dr Andriy Luzhetskyy -
Microbial Natural Products
 Prof Dr Rolf Müller
Prof Dr Rolf Müller -
Microbial Drugs
 Prof Dr Marc Stadler
Prof Dr Marc Stadler -
Molecular Bacteriology
 Prof Dr Susanne Häußler
Prof Dr Susanne Häußler -
Natural Product Biotechnology
 Prof Dr Tobias Gulder
Prof Dr Tobias Gulder -
Pharmacokinetics and Pharmacodynamics
 Dr Katharina Rox
Dr Katharina Rox -
Drug Bioinformatics
 Prof Dr Olga Kalinina
Prof Dr Olga Kalinina -
Drug Design and Optimization
 Prof Dr Anna K. H. Hirsch
Prof Dr Anna K. H. Hirsch

![[Translate to English:] Rasterelektronenmikroskopische Aufnahme einer Escherichia coli-Zelle (rot), die von Bakteriophagen (grün) infiziert wird.](/fileadmin/_processed_/1/6/csm_Escherichia_coli_phage_8c7e69405a.jpg)











![[Translate to English:] Gut bacterium Escherichia coli](/fileadmin/_processed_/1/9/csm_hzi_wiss_ecoli_mr_006__1__332f660d14.jpg)



